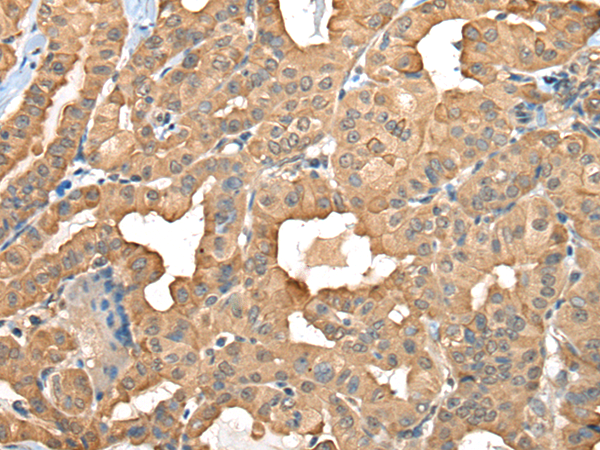

中文名稱:兔抗C1GALT1C1多克隆抗體
|
Background: |
This gene encodes a type II transmembrane protein that is similar to the core 1 beta1,3-galactosyltransferase 1, which catalyzes the synthesis of the core-1 structure, also known as Thomsen-Friedenreich antigen, on O-linked glycans. This gene product lacks the galactosyltransferase activity itself, but instead acts as a molecular chaperone required for the folding, stability and full activity of the core 1 beta1,3-galactosyltransferase 1. Mutations in this gene have been associated with Tn syndrome. Alternatively spliced transcript variants encoding the same protein have been identified. |
|
Applications: |
ELISA, IHC |
|
Name of antibody: |
C1GALT1C1 |
|
Immunogen: |
Fusion protein of human C1GALT1C1 |
|
Full name: |
C1GALT1 specific chaperone 1 |
|
Synonyms: |
TNPS; COSMC; MST143; C1GALT2; HSPC067; C38H2-L1 |
|
SwissProt: |
Q96EU7 |
|
ELISA Recommended dilution: |
5000-10000 |
|
IHC positive control: |
Human thyroid cancer |
|
IHC Recommend dilution: |
50-300 |
購物車
幫助
021-54845833/15800441009
